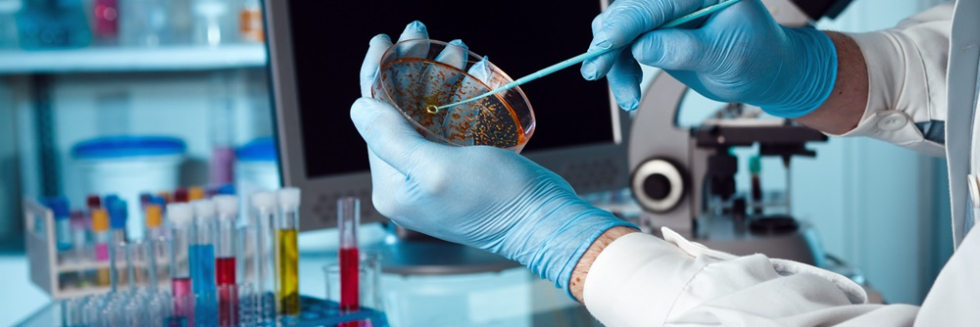

Nouveautés
Faculté
Qualité
Formation
Recherche
Vie estudiantine
Services